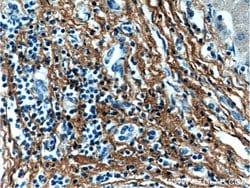
Fibromodulin Mouse anti-Human, Clone: 3E9D10, Proteintech:Antibodies:Primary

missing translation for 'onlineSavingsMsg'
Learn More
Learn More
Fibromodulin Mouse anti-Human, Clone: 3E9D10, Proteintech
Mouse Monoclonal Antibody
1710.33 NOK - 4836.10 NOK
Specifications
| Antigen | Fibromodulin |
|---|---|
| Clone | 3E9D10 |
| Concentration | 1 mg/mL |
| Applications | Immunohistochemistry (Paraffin) |
| Classification | Monoclonal |
| Product Code | Brand | Quantity | Price | Quantity & Availability | |||||
|---|---|---|---|---|---|---|---|---|---|
| Product Code | Brand | Quantity | Price | Quantity & Availability | |||||
|
16847075
|
Proteintech
60108-1-IG-20UL |
20 μL |
1710.33 NOK
20µL |
Please sign in to purchase this item. Need a web account? Register with us today! | |||||
|
16837075
|
Proteintech
60108-1-IG-150UL |
150 μL |
4836.10 NOK
150µL |
Please sign in to purchase this item. Need a web account? Register with us today! | |||||
Description
Fibromodulin is a member of a family of small interstitial proteoglycans, containing a central region composed of leucine-rich repeats with 4 keratan sulfate chains flanked by disulfide-bonded terminal domains. It may participate in the assembly of the extracellular matrix as it interacts with type I and type II collagen fibrils and inhibits fibrillogenesis in vitro. It may also regulate TGF-beta activities by sequestering TGF-beta into the extracellular matrix.Specifications
| Fibromodulin | |
| 1 mg/mL | |
| Monoclonal | |
| Liquid | |
| RUO | |
| PBS with 50% glycerol and 0.1% sodium azide; pH 7.3 | |
| fibromodulin, FM, FMOD, KSPG fibromodulin, SLRR2E | |
| FMOD | |
| IgG1 | |
| Caprylic Acid Precipitation | |
| Antibody |
| 3E9D10 | |
| Immunohistochemistry (Paraffin) | |
| Unconjugated | |
| Mouse | |
| Human | |
| Q06828 | |
| 2331 | |
| Fibromodulin Fusion Protein Ag4030 | |
| Primary | |
| -20°C | |
| FMOD |
Spot an opportunity for improvement?Share a Content Correction
Product Content Correction
Your input is important to us. Please complete this form to provide feedback related to the content on this product.
Product Title